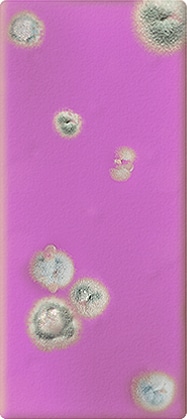

Per dip slide, you also receive 2 individually wrapped sterile cotton swabs. You use 1 cotton swab per dip slide side. Cosmetic products such as creams, lotions and shampoos are used daily by consumers and therefore must be of high quality and safe to use. Yet microbial contamination can be a major problem. This is because bacteria, yeasts and fungi (fungi) can multiply relatively quickly in a moist and nutritious environment. If they grow unchecked, these microorganisms can spoil the product or even make it harmful to the user. Therefore, it is crucial to regularly check that cosmetic products are free of unwanted microorganisms. Cosmetic dipslides offer a simple, reliable and relatively quick way to detect bacteria and fungi, even if you don’t have a specialized laboratory at your disposal. If you would rather have a laboratory do it for you, you can purchase our microbiological laboratory test.
What are cosmetic Dip Slides?
Cosmetic dip slides are thin, plastic paddles that have a nutrient medium (agar) for microorganisms on both sides. They are used to take a sample of your product – for example, a cream or lotion – so that bacteria and fungi present in the sample can develop on the agar. With this method, you get visibility of possible contamination within 24 to 48 hours. Because of their ease of use and speed, dipslides are especially popular with cosmetic manufacturers who do not have a fully equipped laboratory. Instead of complex equipment, all you need is an incubator (or other controllable, warm environment) and the dipslides themselves. This way, you can still perform microbiological tests professionally.
Two agar media: TSA and Rose Bengal
An important feature of cosmetics dipslides is that they contain two different nutrient bases. For example, CRBS cosmetics dipslides have TSA (Tryptic Soy Agar) on one side and Rose Bengal agar on the other.
- TSA (Tryptic Soy Agar): This agar is suitable for culturing a variety of bacterial species. It is often used to determine the Total Viable Count (TVC), or total number of viable bacteria in your sample. If there are bacteria in your cosmetics product, they will form colonies on the TSA side.
- Rose Bengal agar: This medium is designed to promote the growth of yeasts and fungi and often can even be distinguished by the characteristic color of the colonies. It is important to be able to identify yeasts and molds separately because these microorganisms can also cause spoilage and abnormalities in your product.
Both sides of the dipslide are housed in a sterile, gamma-irradiated tube. This ensures that the agar arrives at your door without contamination, so that any growth on the agar actually comes from your product and not the environment.
Application and method
Using cosmetic dipslides is very simple. You can dip the paddle directly into your product or apply the product to the agar using a cotton swab. Then you place the dipslide back into its corresponding tube and put it in an incubator or in a suitable place with the right temperature. Most cosmetic microorganisms grow well at temperatures between 25°C and 37°C, but always check the recommendations in your protocol or manual.
After 24 to 48 hours, you can remove the dipslide from the incubator and assess its growth on the agar. Bacteria often appear as small, round, shiny colonies on the TSA side, while yeasts and fungi usually form fluffy or powdery colonies on the Rose Bengal agar. The color and shape of the colonies can sometimes already give clues about the type of microorganism. If you want more certainty, you may want to do follow-up testing or send the colonies to a specialized laboratory for identification.
Prevention of spoilage and damage
If too many bacteria or mold are present in a cosmetic product, it can lead to spoilage. This manifests itself in changes in odor, color and texture. In some cases, microorganisms or their toxins can even be harmful to the user’s health. For example, a spoiled cream can cause skin irritations or allergic reactions. There is also a risk for the manufacturer that unsafe products will enter circulation, leading not only to dissatisfied customers, but also to reputational damage and possible recalls (recalls).
Regular monitoring with dipslides ensures that you notice potential problems in time and can take corrective action. Examples include adjusting your preservation system, tightening hygiene protocols during production or better protecting raw materials and semi-finished products from contamination.
Specific risks in aqueous cosmetics
Not all cosmetic products have the same susceptibility to microbial growth. Powders, such as eye shadows, have a very low water content, which makes it difficult for microorganisms to grow. The situation is different with lotions, emulsions, shampoos and conditioners. These products contain water – sometimes in significant amounts – which can be an ideal food source for bacteria, yeasts and fungi. As a result, aqueous cosmetics are more likely to be contaminated, especially if they are not properly preserved or if care is not taken during production.
It is therefore advisable to be extra vigilant when testing these types of cosmetics. A regular check with dipslides gives you insight into the microbiological status of your product. Should excessive numbers of microorganisms be found, you can intervene before the product is released onto the market. In this way, you prevent consumers from having to deal with spoiled or unsafe products and you run less risk of negative publicity or complaints.
How to use a dip slide
 |
Step 1: Open the pouch with the cotton swab |
 |
Step 2 : Collect the sample |
 |
Step 3: Streak the sample |
 |
Step 4 : Repeat |
 |
Step 5 : Incubate the dipslide |
 |
Step 6 : Compare the results Compare the dipslide with the comparison table and note the amount of growth. |
Tryptone Soya Agar with TTC dip slide side
| Contamination level in liquids/lotion/cream (CFU/ml) | 102 | 103 | 104 | 105 | 106 | 107 |
| Permitted maximum amount of cosmetics(EU Guidelines page 91) | Children <3 Eye area Mucous membranes | Other products | Not allowed | Not allowed | Not allowed | Not allowed |
| Approximate yeast colonies per agar | 2 | 12 | 60 | 200 | 500 | 600+ |
| Example image |  |  |  |  |  |  |
| Contamination level on surfaces (CFU/cm2) | 0.4 | 2.5 | 12 | 40 | 100 | 250 |
Rose Bengal dip slide lace
| Contamination level in liquids/lotion/cream (CFU/ml) | 102 | 103 | 104 | 105 | 106 | 107 |
| Permitted maximum amount of cosmetics(EU Guidelines page 91) | Children <3 Eye area Mucous membranes | Other products | Not allowed | Not allowed | Not allowed | Not allowed |
| Approximate yeast colonies per agar | 2 | 12 | 60 | 200 | 500 | 600+ |
| Example image |  |  |  |  |  |  |
| Contamination level on surfaces (CFU/cm2) | 0.4 | 2.5 | 12 | 40 | 100 | 250 |
| Level of fungi | Light | Medium | Heavy |
| Example image |  | |  |
Specifications dip slide and cotton swabs
Cosmetic dip slide
Front Agar type: Tryptone Soya (TSA) (Cosmetic formulation)
Front Agar color: yellow
Front Agar growth: total count (TTC/red spot)
Back Agar type: Rose Bengal (Cosmetic formulation)
Back side Agar color: pink
Back side Agar growth: yeasts and fungi
Certification: ISO 9001
Recommended incubation times: 24 – 120 hours
Recommended incubation temp: 30°C
Sterile Dryswab™ packaged in individual dispensing bags
Packaging : pouch
Applicator material : wood
Certifications/conformity : CE-marked 1639 in accordance with the Medical Devices Directive93/42/EEC.
To be used with (Application) : for sample collection, transport and general laboratory use.
Sterile : R
Material tip : cotton
Storage temperature: 5-25°C.











Reviews
There are no reviews yet.